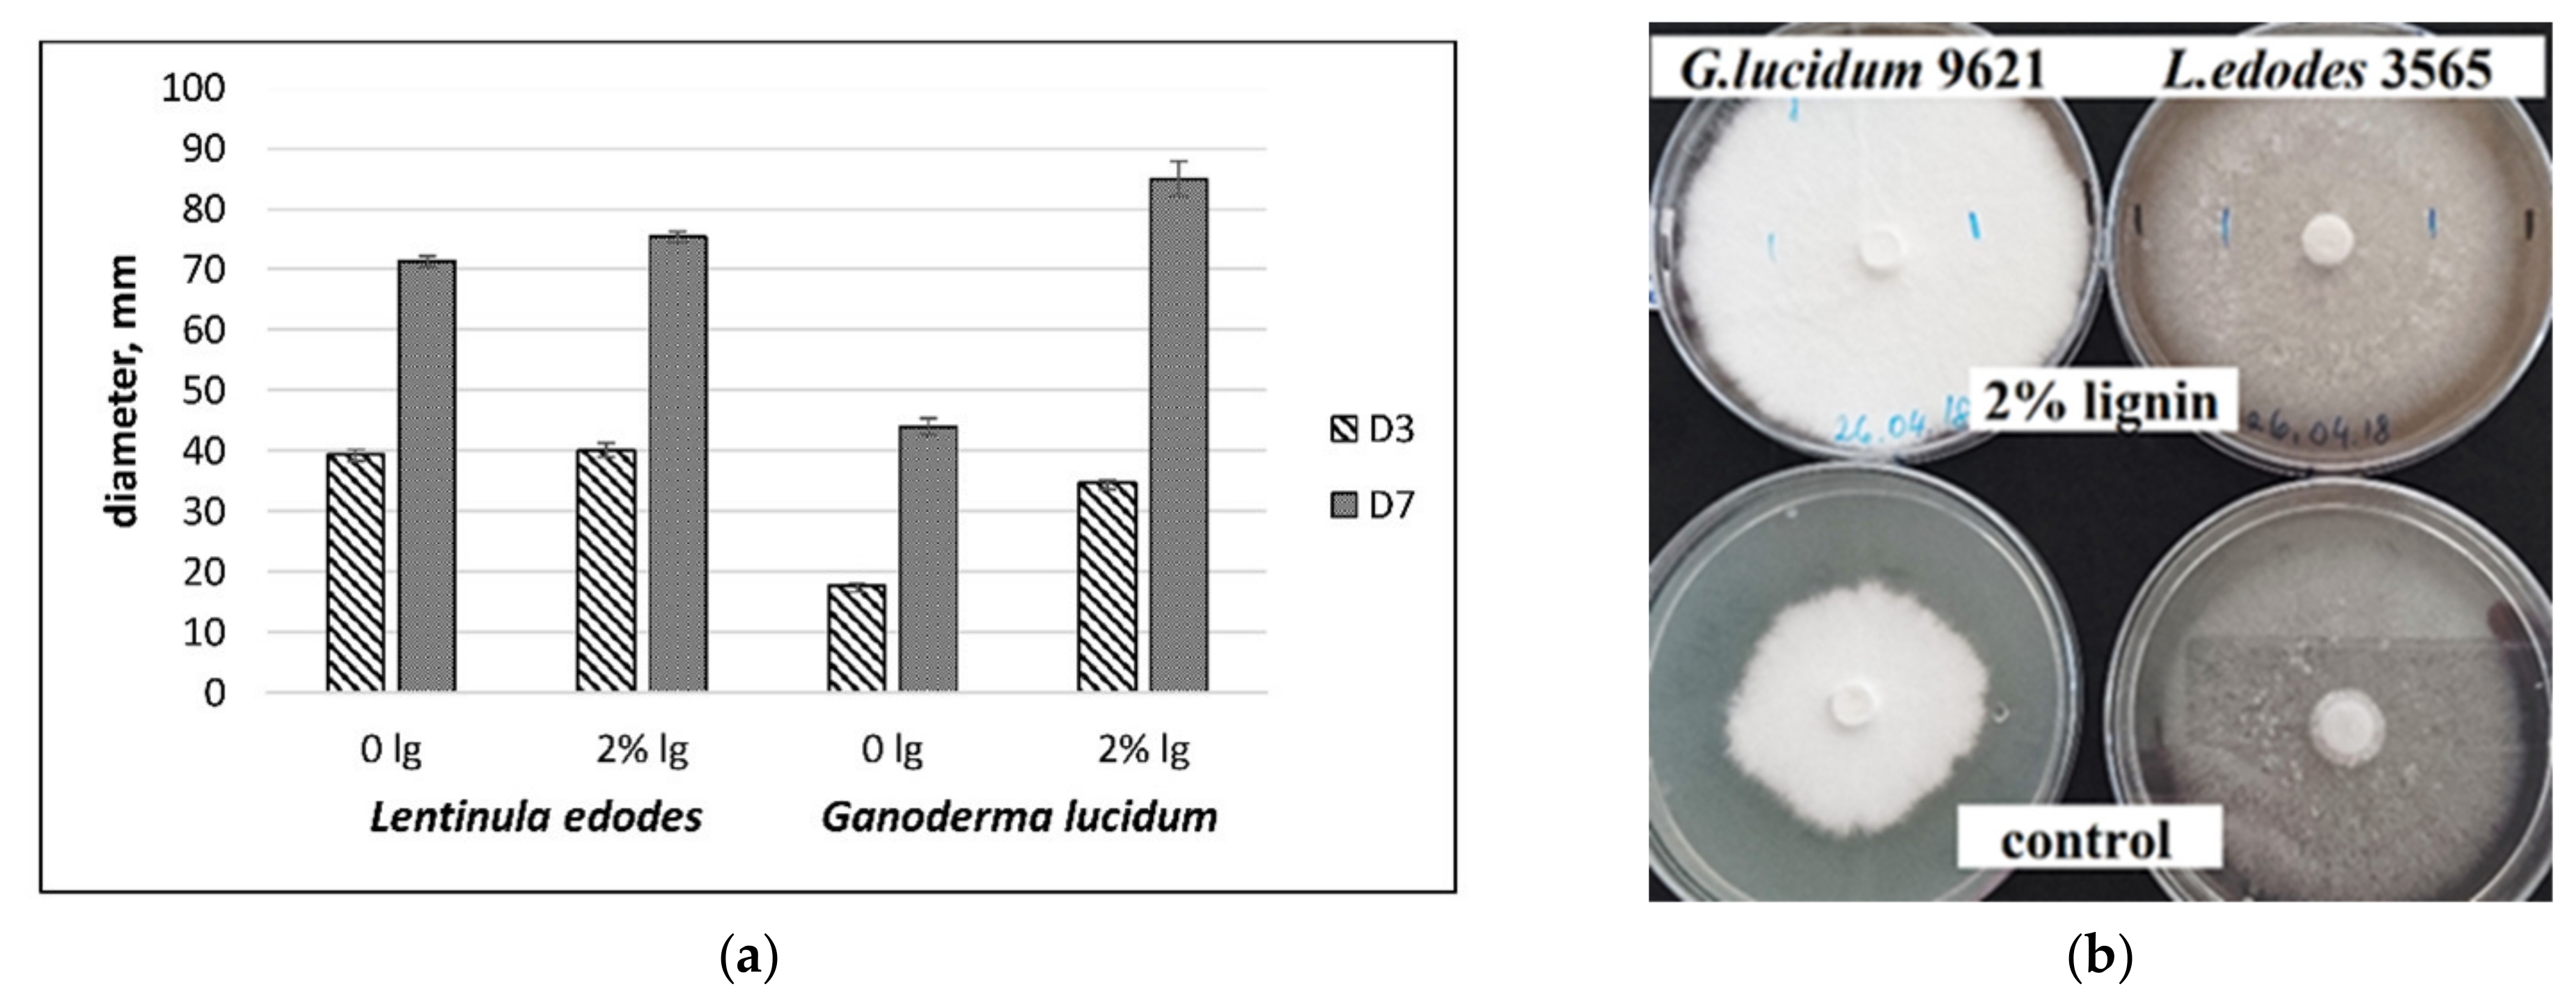
Fermentation 07 00157 g001

Effect of Pretreated Colza Straw on the Growth and Extracellular Ligninolytic Enzymes Production by Lentinula edodes and Ganoderma lucidum
Abstract
1. Introduction
2. Materials and Methods
2.1. Reagents
2.2. Fungal Strains and Culture Conditions
2.3. Substrate for Mycelium
2.4. Determination of Dry Weight
2.5. Enzyme Assays
2.6. Zymogram Analysis
2.7. Statistical Analysis
3. Results and Discussion
3.1. Mycelial Growth on Pretreated Colza Straw
3.2. Cultivation in SM with Agitation and SL Media for Laccase Production
3.3. Native PAGE
4. Conclusions
Author Contributions
Funding
Institutional Review Board Statement
Informed Consent Statement
Data Availability Statement
Conflicts of Interest
References
- Rapoport, A.; Vedernikov, N.; Kruma, I.; Puke, M.; Borovikova, D.; Rozenfelde, L.; Khroustalyova, G.; Matyuskova, N. Waste-less bioethanol and other valuable substances production from hardwood. WIT Trans. Eng. Sci. 2014, 88, 311–317. [Google Scholar] [CrossRef]
- Brandenburg, J.; Poppele, I.; Blomqvist, J.; Puke, M.; Pickova, J.; Sandgren, M.; Rapoport, A.; Vedernikovs, N.; Passoth, V. Bioethanol and lipid production from the enzymatic hydrolysate of wheat straw after furfural extraction. Appl. Microbiol. Biotechnol. 2018, 102, 6269–6277. [Google Scholar] [CrossRef] [PubMed]
- López-Linares, J.C.; Ballesteros, I.; Tourán, J.; Cara, C.; Castro, E.; Ballesteros, M.; Romero, I. Optimization of uncatalyzed steam explosion pretreatment of rapeseed straw for biofuel production. Bioresour. Technol. 2015, 190, 97–105. [Google Scholar] [CrossRef]
- Rozenfelde, L.; Puke, M.; Vedernikovs, N.; Scherbaka, R.; Rapoport, A. Catalytic treatment of rapeseed straw for enhanced production of furfural and glucose for bioethanol production. Process. Biochem. 2021, 102, 102–107. [Google Scholar] [CrossRef]
- Matjuskova, N.; Okmane, L.; Zala, D.; Rozenfelde, L.; Puke, M.; Kruma, I.; Vedernikovs, N.; Rapoport, A. Effect of lignin-containing media on growth of medicinal mushroom Lentinula edodes. Proceeding Latv. Acad. Sci. 2017, 71, 38–42. [Google Scholar] [CrossRef]
- Liao, Y.; Koelewijn, S.-F.; Van den Bossche, G.; Van Aelst, J.; Van den Bosch, S.; Renders, T.; Navare, K.; Nicolaï, T.; Van Aelst, K.; Maesen, M.; et al. A sustainable wood biorefinery for low–carbon footprint chemicals production. Science 2020, 367, 1385–1390. [Google Scholar] [CrossRef] [PubMed]
- Leatham, G.F. Extracellular enzymes produced by the cultivated mushroom Lentinus edodes during degradation of a lignocellulosic medium. Appl. Environ. Microbiol. 1985, 50, 859–867. [Google Scholar] [CrossRef] [PubMed]
- D’Souza, T.M.; Merritt, C.S.; Reddy, C.A. Lignin-modifying enzymes of the white rot basidiomycete Ganoderma lucidum. Appl. Environ. Microbiol. 1999, 65, 5307–5313. [Google Scholar] [CrossRef]
- Saeki, N.; Takeda, H.; Tanesaka, E.; Yoshida, M. Induction of manganese peroxidase and laccase by Lentinula edodes under liquid culture conditions and their isozyme detection by enzymatic staining on native-PAGE. Mycoscience 2011, 52, 132–136. [Google Scholar] [CrossRef][Green Version]
- Martani, F.; Beltrametti, F.; Porro, D.; Branduardi, P.; Lotti, M. The importance of fermentative conditions for the biotechnological production of lignin modifying enzymes from white-rot fungi. FEMS Microbiol. Lett. 2017, 364, 1–18. [Google Scholar] [CrossRef]
- Chen, S.; Xu, J.; Liu, C.; Zhu, Y.; Nelson, D.R.; Zhou, S.; Li, C.; Wang, L.; Guo, X.; Sun, Y.; et al. Genome sequence of the model medicinal mushroom Ganoderma lucidum. Nat. Commun. 2012, 3, 1–9. [Google Scholar] [CrossRef]
- Chen, L.; Gong, Y.; Cai, Y.; Liu, W.; Zhou, Y.; Xiao, Y.; Xu, Z.; Liu, Y.; Lei, X.; Wang, G.; et al. Genome sequence of the edible cultivated mushroom Lentinula edodes (Shiitake) reveals insights into lignocellulose degradation. PLoS ONE 2016, 11, e0160336. [Google Scholar] [CrossRef]
- Hatakka, A. Lignin—Modifying enzymes from selected white—Rot fungi—Production and role in lignin degradation. FEMS Microbiol Rev. 1994, 13, 125–135. [Google Scholar] [CrossRef]
- Tripathi, M.; Mishra, A.; Misra, A.; Vaithiyanathan, S.; Prasad, R.; Jakhmola, R. Selection of white-rot basidiomycetes for bioconversion of mustard (Brassica compestris) straw under solid-state fermentation into energy substrate for rumen microorganism. Lett. Appl. Microbiol. 2008, 46, 364–370. [Google Scholar] [CrossRef]
- Dashtban, M.; Schraft, H.; Qin, W. Fungal Bioconversion of Lignocellulosic Residues; Opportunities & Perspectives. Int. J. Biol. Sci. 2009, 5, 578–595. [Google Scholar] [CrossRef]
- Winquist, E.; Moilanen, U.; Mettälä, A.; Leisola, M.; Hatakka, A. Production of lignin modifying enzymes on industrial waste material by solid-state cultivation of fungi. Biochem. Eng. J. 2008, 42, 128–132. [Google Scholar] [CrossRef]
- Masran, R.; Zanirun, Z.; Bahrin, E.K.; Ibrahim, M.F.; Lai Yee, P.; Abd-Aziz, S. Harnessing the potential of ligninolytic enzymes for lignocellulosic biomass pretreatment. Appl. Microbiol. Biotechnol. 2016, 100, 5231–5246. [Google Scholar] [CrossRef]
- Zhong, J.J.; Tang, Y.-J. Submerged Cultivation of Medicinal Mushrooms for Production of Valuable Bioactive Metabolites. Adv. Biochem. Eng. Biotechnol. 2004, 87, 25–59. [Google Scholar] [CrossRef]
- Yang, F.C.; Liau, C.B. Effects of cultivating conditions on the mycelial growth of Ganoderma lucidum in submerged flask cultures. Bioprocess. Eng. 1998, 19, 233–236. [Google Scholar] [CrossRef]
- Berović, M.; Habijanić, J.; Zore, I.; Wraber, B.; Hodžar, D.; Boh, B.; Pohleven, F. Submerged cultivation of Ganoderma lucidum biomass and immunostimulatory effects of fungal polysaccharides. J. Biotechnol. 2003, 103, 77–86. [Google Scholar] [CrossRef]
- Elisashvili, V. Submerged cultivation of medicinal mushrooms: Bioprocesses and products (review). Int. J. Med. Mushrooms 2012, 14, 211–239. [Google Scholar] [CrossRef] [PubMed]
- Lin, S.Y.; Chen, Y.; Yu, H.; Barseghyan, G.S.; Asatiani, M.D.; Wasser, S.P.; Mau, J.L. Comparative Study of Contents of Several Bioactive Components in Fruiting Bodies and Mycelia of Culinary-Medicinal Mushrooms. Int. J. Med. Mushrooms 2013, 15, 315–323. [Google Scholar] [CrossRef] [PubMed]
- Grienke, U.; Kaserer, T.; Pfluger, F.; Mair, C.E.; Langer, T.; Schuster, D.; Rollinger, J.M. Accessing biological actions of Ganoderma secondary metabolites by in silico profiling. Phytochemistry 2015, 114, 114–124. [Google Scholar] [CrossRef] [PubMed]
- Kała, K.; Kryczyk-Poprawa, A.; Rzewińska, A.; Muszyńska, B. Fruiting bodies of selected edible mushrooms as a potential source of lovastatin. Eur. Food Res. Technol. 2020, 246, 713–722. [Google Scholar] [CrossRef]
- Hofrichter, M.; Vares, T.; Kalsi, M.; Galkin, S.; Scheibner, K.; Fritsche, W.; Hatakka, A. Production of manganese peroxidase and organic acids and mineralization of 14C-labelled lignin (14C-DHP) during solid-state fermentation of wheat straw with the white rot fungus Nematoloma frowardii. Appl. Environ. Microbiol. 1999, 65, 1864–1870. [Google Scholar] [CrossRef]
- Mata, G.; Delpech, P.; Savoie, J.M. Selection of strains of Lentinula edodes and Lentinula boryana adapted for efficient mycelial growth on wheat straw. Rev. Iberoam. Micol. 2001, 18, 118–122. [Google Scholar]
- Nagai, M.; Sato, T.; Watanabe, H.; Saito, K.; Kawata, M.; Enei, H. Purification and characterization of an extracellular laccase from the edible mushuroom Lentinula edodes, and decolorization of chemically different dyes. Appl. Microbiol. Biotechnol. 2002, 60, 327–335. [Google Scholar] [CrossRef]
- Gaitán-Hernández, R.; Esqueda, M.; Gutiérrez, A.; Sánchez, A.; Beltrán-García, M.; Mata, G. Bioconversion of agrowastes by Lentinula edodes: The high potential of viticulture residues. Appl. Microbiol. Biotechnol. 2006, 71, 432–439. [Google Scholar] [CrossRef]
- Sánchez, C. Lignocellulosic residues: Biodegradation and bioconversion by fungi. Biotechnol. Adv. 2009, 27, 185–194. [Google Scholar] [CrossRef]
- Asgher, M.; Bhatti, H.N.; Ashraf, M.; Legge, R.L. Recent developments in biodegradation of industrial pollutants by white rot fungi and their enzyme system. Biodegradation 2008, 19, 771–783. [Google Scholar] [CrossRef]
- Sharma, R.; Arora, D. Changes in biochemical constituents of paddy straw during degradation by white rot fungi and its impact on in vitro digestibility. J. Appl. Microbiol. 2010, 109, 679–686. [Google Scholar] [CrossRef]
- Manavalan, T.; Manavalan, A.; Thangavelu, K.P.; Heese, K. Secretome analysis of Ganoderma lucidum cultivated in sugarcane bagasse. J. Proteom. 2012, 77, 298–309. [Google Scholar] [CrossRef]
- Wan, C.; Li, Y. Fungal pretreatment of lignocellulosic biomass. Biotechnol. Adv. 2012, 30, 1447–1457. [Google Scholar] [CrossRef]
- Niku-Paavola, M.; Raaska, L.; Itavaara, M. Detection of white-rot fungi by a non-toxic stain. Mycol. Res. 1990, 94, 27–31. [Google Scholar] [CrossRef]
- Buswell, J.A.; Cai, Y.; Chang, S.T. Effect of nutrient nitrogen and manganese on manganese peroxidase and laccase production by Lentinula (Lentinus) edodes. FEMS Microbiol. Lett. 1995, 128, 81–88. [Google Scholar] [CrossRef]
- Laemmli, U.K. Cleavage of structural proteins during the assembly of the head of bacteriophage T4. Nature 1970, 227, 680–685. [Google Scholar] [CrossRef]
- Butler, M.J.; Lachance, M.A. The use of N,N,N’,N’-tetramethylphenylenediamine to detect peroxidase activity on polyacrylamide electrophoresis gels. Anal. Biochem. 1987, 162, 443–445. [Google Scholar] [CrossRef]
- Yang, F.C.; Yang, M.-J.; Cheng, C.H. A novel method to enhance the mycelia production of Ganoderma lucidum in submerged cultures by polymer additives and agitation strategies. J. Taiwan Inst. Chem. Eng. 2009, 40, 148–154. [Google Scholar] [CrossRef]
- Fraga, I.; Coutinho, J.; Bezerra, R.M.; Dias, A.; Marques, G.; Nunes, F. Influence of culture medium growth variables on Ganoderma lucidum exopolysaccharides structural features. Carbohydr. Polym. 2014, 111, 936–946. [Google Scholar] [CrossRef]
- Vares, T.; Kalsi, M.; Hatakka, A. Lignin peroxidases, manganese peroxidases, and other ligninolytic enzymes produced by Phlebia radiata during solid-state fermentation of wheat straw. Appl. Environ. Microbiol. 1995, 61, 3515–3520. [Google Scholar] [CrossRef]
- Makkar, R.S.; Tsuneda, A.; Tokuyasu, K.; Mori, Y. Lentinula edodes produces a multicomponent protein complex containing manganese (II)-dependent peroxidase, laccase and beta-glucosidase. FEMS Microbiol Lett. 2001, 200, 175–179. [Google Scholar] [CrossRef]
- De Souza Silva, C.M.M.; De Melo, I.S.; De Oliveira, P.R. Ligninolytic enzyme production by Ganoderma spp. Enzym. Microb. Technol. 2005, 37, 324–329. [Google Scholar] [CrossRef]
- Sitarz, A.; Mikkelsen, J.; Højrup, P.; Meyer, A. Identification of a laccase from Ganoderma lucidum CBS 229.93 having potential for enhancing cellulase catalyzed lignocellulose degradation. Enzym. Microb. Technol. 2013, 53, 378–385. [Google Scholar] [CrossRef]
- Elisashvili, V.; Kachlishvili, E.; Asatiani, M. Shiitake medicinal mushroom, Lentinus edodes (Higher Basidiomycetes) productivity and lignocellulolytic enzyme profiles during wheat straw and tree leaf bioconversion. Int. J. Med. Mushrooms 2015, 17, 77–86. [Google Scholar] [CrossRef]
- Cai, Y.; Gong, Y.; Liu, W.; Hu, Y.; Chen, L.; Yan, L.; Zhou, Y.; Bian, Y. Comparative secretomic analysis of lignocellulose degradation by Lentinula edodes grown on microcrystalline cellulose, lignosulfonate and glucose. J. Proteom. 2017, 163, 92–101. [Google Scholar] [CrossRef]
- Stajić, M.; Kukavica, B.; Vukojević, J.; Simonić, J.; Veljović-Jovanović, S.; Duletić-Laušević, S. Wheat straw conversion by enzymatic system of Ganoderma lucidum. Bioresources 2010, 5, 2362–2373. [Google Scholar] [CrossRef]
- Hariharan, S.; Nambisan, P. Optimization of Lignin Peroxidase, Manganese Peroxidase, and Lac Production from Ganoderma lucidum Under Solid State Fermentation of Pineapple Leaf. Bioresources 2013, 8, 250–271. [Google Scholar] [CrossRef]
- Kumar, A.; Singh, D.; Sharma, K.K.; Arora, S.; Singh, A.K.; Gill, S.S.; Singhal, B. Gel-Based Purification and Biochemical Study of Laccase Isozymes from Ganoderma sp. and Its Role in Enhanced Cotton Callogenesis. Front. Microbiol. 2017, 8, 674. [Google Scholar] [CrossRef]
- Cavallazzi, J.; Oliveira, M.; Kasuya, M. Screening of inducers for laccase production by Lentinula edodes in liquid medium. Braz. J. Microbiol. 2005, 36, 383–387. [Google Scholar] [CrossRef]
- Ko, E.M.; Leem, Y.E.; Choi, H.T. Purification and characterization of laccase isozymes from the white-rot basidiomycete Ganoderma lucidum. Appl. Microbiol. Biotechnol. 2001, 57, 98–102. [Google Scholar] [CrossRef]

Publisher’s Note: MDPI stays neutral with regard to jurisdictional claims in published maps and institutional affiliations. |
© 2021 by the authors. Licensee MDPI, Basel, Switzerland. This article is an open access article distributed under the terms and conditions of the Creative Commons Attribution (CC BY) license (https://creativecommons.org/licenses/by/4.0/).
Share and Cite
Makarenkova, G.; Balode, V.; Zala, D.; Azena, E.; Rapoport, A.; Muiznieks, I. Effect of Pretreated Colza Straw on the Growth and Extracellular Ligninolytic Enzymes Production by Lentinula edodes and Ganoderma lucidum. Fermentation 2021, 7, 157. https://doi.org/10.3390/fermentation7030157
Makarenkova G, Balode V, Zala D, Azena E, Rapoport A, Muiznieks I. Effect of Pretreated Colza Straw on the Growth and Extracellular Ligninolytic Enzymes Production by Lentinula edodes and Ganoderma lucidum. Fermentation. 2021; 7(3):157. https://doi.org/10.3390/fermentation7030157
Chicago/Turabian StyleMakarenkova, Galina, Valda Balode, Dzintra Zala, Elina Azena, Alexander Rapoport, and Indrikis Muiznieks. 2021. "Effect of Pretreated Colza Straw on the Growth and Extracellular Ligninolytic Enzymes Production by Lentinula edodes and Ganoderma lucidum" Fermentation 7, no. 3: 157. https://doi.org/10.3390/fermentation7030157
APA StyleMakarenkova, G., Balode, V., Zala, D., Azena, E., Rapoport, A., & Muiznieks, I. (2021). Effect of Pretreated Colza Straw on the Growth and Extracellular Ligninolytic Enzymes Production by Lentinula edodes and Ganoderma lucidum. Fermentation, 7(3), 157. https://doi.org/10.3390/fermentation7030157

